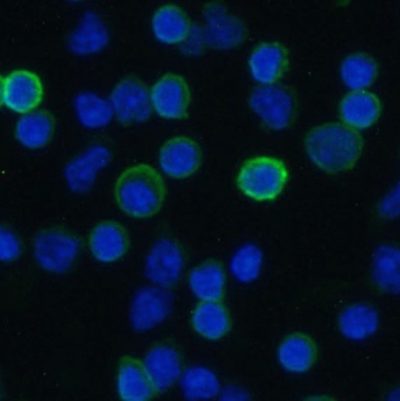
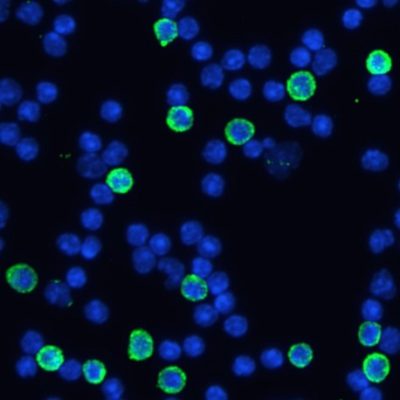
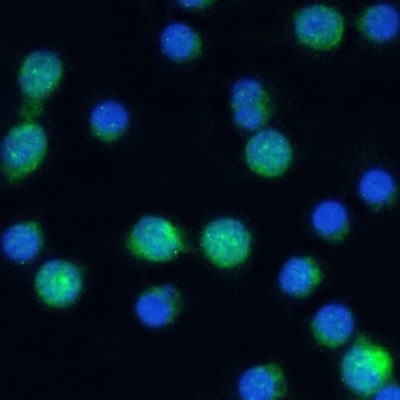

Unit Size Pack of 50 | |
Shipping Instructions Ambient |
SB-SHIFIX50 Coverslips
Shi-fix ™ coverslips
Do you wish immunofluorescence of suspension cells was as easy as with adherent cells? Now it is! Shi-fix™ (manufactured by Shikhar Biotech) cover-slips allow suspension cells to be layered on them or directly grown as a monolayer. Easy, hassle-free protocol and no spin columns needed for fixing suspension cells to slides. Just add your cells to the coverslips, wait for 30 mins, wash unbound cells with PBS and proceed to immunostaining (or continue the culture to obtain desired cell densities).
These cover-slips can also be used for staining suspension cells for microscopy, or for fixing suspension cells for confocal microscopy. What’s more, you can also stimulate the cells while they are attached on the cover-slip, should you need to do so. You can work on non-adherent cells as if they were adherent!
Suspension cell immunofluorescence with Shi-fix™ coverslips
Size: ø 12mm x 0.17mm(#1.5)
$270.00
| SKU | Unit Size | Price |
|---|---|---|
Select a unit size: